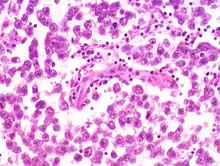

Злокачественные новообразования яичка
Злокачественные новообразования яичка — злокачественные опухоли, берущие начало из тканей мужской половой железы — яичка. Относятся к редко встречающимся видам рака, их доля среди всех злокачественных опухолей у мужчин составляет около 2 %[3]. В отличие от рака других органов, рак яичка чаще встречается в молодом возрасте (25—35 лет), доходя в некоторых странах до уровня самой часто встречающейся опухоли у мужчин до 50 лет.
| Злокачественные новообразования яичка | |
|---|---|
![]() Семинома яичка | |
| МКБ-11 | 2C80 |
| МКБ-10 | C62 |
| МКБ-10-КМ | C62, C62.9 и C62.90 |
| МКБ-9 | 186.9 |
| МКБ-9-КМ | 186[1] и 239.5[2] |
| OMIM | 273300 |
| DiseasesDB | 12966 |
| MedlinePlus | 001288 |
| eMedicine | med/2250 |
Благодаря использованию современных схем химиотерапии, лучевой терапии и хирургических методов лечения, рак яичка в большинстве случаев хорошо поддаётся лечению, особенно при своевременной диагностике при первых проявлениях[4].
Существует множество других заболеваний, которые могут вызывать боль и припухлость, не имея отношения к раку: эпидидимит, кисты и перекрут яичка, тестикулярный микролитиаз и пр.
Разновидности
Большинство новообразований яичек злокачественного характера относится к эмбриональноклеточным опухолям, а именно:
- Семинома (около 38%). Инвазивная злокачественная опухоль, построенная из герминогенного атипичного эпителия. Встречается наиболее часто, довольно рано даёт метастазы. Нередко сопровождается некрозами.[5] Поражает всё яичко, оставляя свободным только узкое кольцо нормальной ткани между опухолью и белочной оболочкой.[6]
- Эмбриональноклеточный рак (32%)
- Тератомы (26%)
- Хорионкарциномы (2%)
Возможен вариант опухоли, в которой сочетаются различные гистологические элементы. Известны также злокачественные опухоли яичек иной природы:
- Лимфомы;
- Острые инфильтраты при лимфолейкозах;
- Метастатические поражения (при меланоме, раке простаты, раке лёгких и почек).
Эпидемиология

Опухоли яичка поражают исключительно мужчин и являются относительно редкими новообразованиями: их удельный вес в структуре онкологической заболеваемости лишь немногим превышает 1%. В то же время, применительно к мужчинам молодого возраста, именно рак яичка является у них наиболее частой онкологической патологией (до 60% от всех новообразований), а также основной причиной онкологической смертности.[7]
За последние 40 лет заболеваемость тестикулярными опухолями почти удвоилась. Самые большие показатели заболеваемости — в Западной (7,8%) и Северной Европе (6,7%), Австралии (6,5%), Северной Америке (6,5%), самые низкие — в Азии (0,5—1,5%) и Африке (0,2—0,7%).[8] В России показатель заболеваемости составляет около 1,72 случая на 100 тысяч населения в год. Самая высокая заболеваемость наблюдается в Приволжском и Северо-Западном федеральных округах, самые низкие показатели в Северо-Кавказском федеральном округе. В Москве и Санкт-Петербурге заболеваемость составляет 1, 37 и 1,79 случаев на 100 000 человек соответственно.[9]
Факторы риска
- Присутствие пренеопластического процесса в яичке (карцинома in situ, или внутриканальцевая герминогенная неоплазия неклассифицированного типа (intratubular germ cell neoplasia, unclassified type; IGCNU) — один из наиболее значимых факторов риска. Является типичным морфологическим предшественником инвазивных опухолей, содержит определённый спектр онкоассоциированных мутаций и представляет существенную опасность для пациента в случае последующей малигнизации.
- Наследственность — существенно увеличивает вероятность появления опухоли присутствие герминогенных опухолей у кровных родственников. Тем не менее, случаи семейной истории заболевания достаточно редки. Вертикальная передача риска герминогенных опухолей может происходить не по доминантному, а по рецессивному или полигенному типам наследования.[10]
- Факт предшествующей герминогенной опухоли. У многих заболевших данная патология может возникать повторно.[7]
- Крипторхизм — предполагается, что сочетание крипторхизма и предрасположенности к опухолям яичка может быть связано с общими этиологическими и патогенетическими факторами, однако не исключается и причинно-следственная связь между аномалиями развития семенников и последующим возникновением опухолей.
- Возраст — подавляющая часть неоплазм яичка диагностируется между 25 и 35 годами.
- Расстройства, ассоциированные с признаками бисексуальности, в том числе с гиперэстрогенией, предрасполагают к развитию опухолей яичка (синдром Кляйнфельтера, с кариотипом XXY, XXXY или XXXXY наибольшей степени ассоциирован с экстрагонадной локализацией герминогенных опухолей).[11]
- Возможный фактор риска — употребление большого количества молочных продуктов.[7]
Курение не увеличивает риск развития герминогенных опухолей: тестикулярные новообразования возникают в относительно молодом возрасте, т.е. задолго до накопления критической дозы канцерогенов табачного дыма.[7]
Существует мнение, что травма яичка предрасполагает к развитию рака, однако несколько многоцентровых исследований опровергли этот факт.[3]
Клиническая классификация по TNM
В данной категории присутствует принятая в медицине терминология, где Т — описывает опухоль и её размер, N — наличие метастазов и их характер в лимфатических узлах, M — отдалённое метастазирование. S — опухолевые маркеры сыворотки, pT — первичная опухоль, pTX — патолого-анатомическая классификация, недостаточно данных.
| Стадия 0 | pTis | N0 | M0 | S0, Sx |
|---|---|---|---|---|
| Стадия 1 | pT1—4 | N0 | MO | SX |
| Стадия 1A | pT1 | N0 | MO | SO |
| Стадия 1B | pT1 pT2 pT3 | N0 | MO | SO |
| Стадия 1С | любая pT | N0 | MO | S1-3 [12]. |
| Вторая стадия (Стадия II) | любая pT/TX | N1-3 | MO | Sx |
| Стадия IIА | любая pT/TX | N1 | MO | SO-S1 |
| Стадия IIB | любая pT/TX | N2 | MO | SO-S1 |
| Стадия IIC | любая pT/TX | N3 | MO | SO-S1 |
| Третья стадия (Стадия III) | любая pT/TX | Любая N | M1, М1а [13] | SX |
| Стадия IIIA | любая pT/TX | Любая N | M1,М1а | SO-S1 |
| Стадия IIIB | любая pT/TX | N1-3 | M0,M1,М1а | S2 |
| Стадия IIIС | любая pT/TX | Любая N | M0,M1,М1а,M1b [14] | S3 |
Лечение
Основные успехи в снижении смертности от рака яичек достигнуты благодаря применению комплексного лечения, в которое входит оперативное удаление опухоли с последующей химиотерапией по разным схемам. В связи с молодым возрастом больных важной задачей для хирурга является сохранение репродуктивной функции мужчины. Для этого в практику начинают внедряться органосохраняющие операции с минимальным объемом удалённых тканей.[3] Снизить риск нарушений сперматогенеза позволяет также криоконсервация на предоперационном этапе.
Показания к органосохраняющей операции согласно руководству Европейской урологической ассоциации:[15]
- опухоль единственного яичка или синхронный рак с двусторонним поражением;
- стадия опухоли T1N0M0;
- периферическое расположение опухоли (вне сети яичка).
В качестве метода радикального хирургического лечения рака яичка показала свою эффективность высокая орхофуникулэктомия.[3] По показаниям проводится лимфаденэктомия (удаление лимфоузлов). В последующем пациенту предлагается курс химиотерапии для полного уничтожения возможных остатков опухоли.
Поскольку химиотерапия несёт потенциальную опасность серьёзных отсроченных побочных эффектов, ученые пытаются разработать критерии, по которым можно было бы выделить пациентов, которым химиотерапия не нужна. Так, исследования 177 пациентов с несеминомой I стадии показали, что риск рецидива зависел от нескольких показателей, включая уровень белка CXCL12[16].
Прогноз
Рак яичек хорошо поддаётся лечению на современном этапе. Уровень смертности неуклонно снижается с середины 70-х годов, в основном благодаря успехам комбинированной терапии[3]. Даже при наличии метастазов более 80% больных могут быть вылечены при помощи комбинированной химиотерапии на основе цисплатина.
К группе хорошего прогноза относятся 56% от общего числа больных несеминомными опухолями; пятилетняя выживаемость для этих пациентов составляет 92%. Критерии включения в группу хорошего прогноза при несеминомных опухолях:[17]
- локализация первичной опухоли в яичке / забрюшинном пространстве,
- отсутствие нелёгочных висцеральных метастазов,
- уровень АФП <1,000 нг/мл,
- уровень β-ХГЧ <5,000 МЕ/л (1,000 нг/мл),
- уровень ЛДГ <1,5 х верхняя граница нормы.
К группе хорошего прогноза при семиноме могут быть отнесены 90% больных; пятилетняя выживаемость составляет 86%. Критерии для включения в группу хорошего прогноза при семиноме:
- любая локализация первичной опухоли,
- отсутствие нелёгочных висцеральных метастазов,
- нормальный уровень АФП,
- любой уровень β-ХГЧ,
- любой уровень ЛДГ.
Группа промежуточного прогноза включает 28% больных несеминомными опухолями. Пятилетняя выживаемость составляет 80%. Критерии:
- локализация первичной опухоли – яичко или забрюшинное пространство, отсутствие нелегочных висцеральных метастазов,
- уровень АФП >1,000 и <10,000 нг/мл или
- уровень β-ХГЧ>5,000 и <50,000 МЕ/л или
- уровень ЛДГ>1,5 и <10х верхней границы нормы.
Среди больных семиномой к группе промежуточного прогноза могут быть отнесены всего 10%; пятилетняя выживаемость отмечается у 72%. Критерии этой группы:
- любая локализация первичной опухоли,
- наличие нелегочных висцеральных метастазов,
- нормальный уровень АФП,
- любой уровень ХГ,
- любой уровень ЛДГ.
Группу плохого прогноза составляют 16% больных несеминомными опухолями. Показатель пятилетней выживаемости для пациентов этой группы составляет только 48%. Критериями включения являются:
- локализация первичной опухоли в средостении,
- наличие нелегочных висцеральных метастазов,
- уровень АФП >10,000 нг/мл или
- уровень β-ХГЧ >50,000 МЕ/л (10,000 нг/мл) или
- уровень ЛДГ > 10х верхней границы нормы.
Восстановление репродуктивной функции
Восстановление функции яичек (сперматогенеза) наблюдается как минимум у половины больных после окончания химиотерапии.[18] Индивидуальный прогноз для каждого пациента дать невозможно, поэтому большинство онкологов считают, что все больные репродуктивного возраста должны перед лечением проходить процедуру криоконсервации.[19]
Примечания
- база данных Disease ontology (англ.) — 2016.
- Monarch Disease Ontology release 2018-06-29sonu — 2018-06-29 — 2018.
- Лоран О. Б., Богданов А.Б. и др. Радикальные и органосохраняющие операции при злокачественных новообразованиях яичка // Анналы хирургии. — 2014. — № 1.
- Джонс В. Г. Рак яичка: клиническая картина и стадия заболевания //Герминогенные опухоли яичка: биология, клиника, диагностика, лечение. М. – 2000.
- Под ред.Серова В.В., Пальцева М.А. Патологическая анатомия. Курс лекций.. — Москва: Медицина, 1998. — С. 271-272. — 640 с.
- Руммени Э.Й. Магнитно-резонансная томография тела : [рус.] / Петер Раймер, Вальтер Хайндель, пер. с англ под общ. ред. докт. мед. наук, проф. Г.Г.Кармазановского. — М. : МЕДпресс-информ, 2014. — С. 503. — 848 с. — ISBN 978-5-00030-182-1.
- Имянитов Е. Н. Эпидемиология и биология герминогенных опухолей // Практическая онкология. — 2006. — Т. 7, № 1-2006.
- Ferlay J., Shin H., Bray F., Forman D., Mathers C., Parkin D. GLOBOCAN 2008, cancer incidence and mortality worldwide: IARC Cancer Base No. 10. Lyon, France: International Agency for Research on Cancer; 2010.
- Чиссов В. И., Старинский В. В., Петрова Г. В. Злокачественные новообразования в России в 2010 году (заболеваемость и смертность) //М.: ФГБУ «МНИОИ им. ПА Герцена» Минздравсоцразвития России. – 2012. – С. 12.
- Lutke Holzik M.F., Rapley E.A., Hoekstra H.J. et al. Genetic predisposition to testicular germcell tumours // Lancet Oncol. – 2004. – Vol.5. – P.363-371
- Schmoll H.J. Extragonadal germ cell tumors // Ann. Oncol. – 2002. – Vol.13 (Suppl. 4) . – P.265-272.
- S1-ЛДГ менее 1,5х, S2 ЛДГ более 1,5 до 10х, S3 — более 10х
- Метастазы в лёгких или выше диафрагмы
- метастазы в печень, головной мозг
- Heidenreich A., Weissbach L., Holth W. et al. German testicular cancer study group. Organ sparing surgery for malignant germ cell tumour of the testis. J. Urol. 2001; 166 (6): 2161-5.
- New test could make chemo unnecessary for many with testicular cancer (англ.). www.medicalnewstoday.com. Дата обращения: 23 мая 2020.
- Воробьев А. В., Носов А. К. Диагностика герминогенных опухолей яичка, стадирование, факторы прогноза //Практ онкол. – 2006. – Т. 25. – №. 1. – С. 16-23. Архивная копия от 5 сентября 2015 на Wayback Machine
- Lampe H., Horwich A., Norman A. et al. Fertility after chemotherapy for testicular germ cell cancers // J. Clin. Oncol. – 1997. – Vol. 15. – P. 239-245
- Magelssen H., Haugen T.B., von During V. et al. Twenty Years Experience with Semen Cryopreservation in Testicular Cancer Patients: Who Needs It? // Europ. Urol. – 2005. – Vol.48. – P. 779-785
